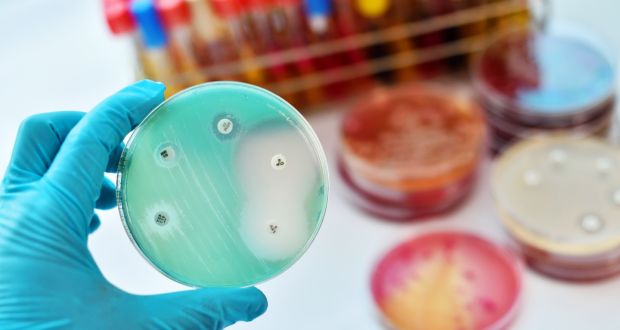
Tr&iacute; tuệ nh&acirc;n tạo vừa t&igrave;m ra một loại si&ecirc;u kh&aacute;ng sinh mới, c&oacute; thể ti&ecirc;u diệt vi khuẩn kh&aacute;ng kh&aacute;ng sinh nguy hiểm nhất - Ảnh 1.

Trí tuệ nhân tạo vừa tìm ra một loại siêu kháng sinh mới, có thể tiêu diệt vi khuẩn kháng kháng sinh nguy hiểm nhất
Trí tuệ nhân tạo đã giúp các nhà nghiên cứu thực hiện được những điều không tưởng.
Các nhà nghiên cứu đã sử dụng trí tuệ nhân tạo, để tạo ra một bước đột phá lớn trong việc khắc chế các loại vi khuẩn kháng kháng sinh nguy hiểm nhất thế giới. Chỉ mất vài giờ, thuật toán đã có thể tìm ra một loại siêu kháng sinh mới, có thể tiêu diệt vi khuẩn kháng kháng sinh nguy hiểm nhất.
Các thử nghiệm cho thấy loại kháng sinh mới có thể tiêu diệt các chủng vi khuẩn kháng kháng sinh, bao gồm Acinetobacter và Enterobacteriaceae. Đây là hai trong số 3 chủng thuộc mức độ cảnh báo, mà Tổ chức Y tế Thế giới WHO xếp vào danh mục vi khuẩn kháng kháng sinh mới.
Đây là loại kháng sinh lần đầu tiên được tìm thấy trong lịch sử. Nhà nghiên cứu Regina Barzilay tại MIT cho biết: “Tôi nghĩ rằng đây là loại kháng sinh mạnh nhất mà đã được tạo ra cho đến nay. Nó có thể tiêu diệt được một số loại vi khuẩn kháng kháng sinh nguy hiểm”.
Để có thể tìm ra loại kháng sinh mới, trước tiên các nhà nghiên cứu phải dạy một thuật toán deep learning của Google, để xác định các loại phân tử nào có thể tiêu diệt vi khuẩn. Để làm được điều này, họ phải cung cấp thông tin về các tính năng nguyên tử và phân tử của gần 2.500 loại thuốc và hợp chất tự nhiên, cho AI có thể nghiên cứu.
Sau khi đã nhập đủ dữ liệu, các nhà nghiên cứu cho AI bắt đầu làm việc để tìm ra loại kháng sinh mới. Tuy nhiên thay vì tập trung vào tìm kiếm một loại kháng sinh có hiệu quả, thuật toán sẽ tập trung vào việc tìm một loại kháng sinh chưa từng có. Đó là mấu chốt để tiêu diệt được những con vi khuẩn kháng kháng sinh hiện nay.
Để mở rộng và tìm kiếm thêm nhiều loại kháng sinh mới mạnh mẽ hơn, các nhà nghiên cứu đã chuyển sang một cơ sở dữ liệu khổng lồ với khoảng 1,5 tỷ hợp chất. Họ cho thuật toán làm việc với khoảng 107 triệu hợp chất trong số đó. Sau 3 ngày, AI đã cho ra một danh sách gồm 23 loại kháng sinh mới đầy tiềm năng.
Người đứng đầu dự án nghiên cứu, tiến sĩ Jonathan Stokes cho biết rằng không thể nào sàng lọc tất cả 107 triệu hợp chất theo phương pháp thủ công. Trí tuệ nhân tạo đã giúp thực hiện điều không tưởng này, và thu ngắn thời gian chỉ còn vài ngày.
Kháng kháng sinh là một vấn đề đáng lo ngại, nếu không có các loại kháng sinh mới thì 10 triệu người trên khắp thế giới có thể gặp rủi ro mỗi năm do nhiễm trùng. Thế nhưng với trí tuệ nhân tạo, nỗi lo này sẽ sớm được giải quyết.
Tham khảo: irishtimes
NỔI BẬT TRANG CHỦ
-
NVIDIA bỏ xa đối thủ 9 lần trong bài kiểm tra AI Jensen Huang gọi là "khắt khe nhất", và lý do không phải chip Blackwell mới
Trong kỳ MLPerf Inference v6.0, NVIDIA là nhà sản xuất duy nhất nộp kết quả DeepSeek-R1 — đồng thời ghi nhận mức tăng 2,7 lần thông lượng token chỉ nhờ cập nhật phần mềm, không thay đổi phần cứng.
-
Mô hình toán học của MIT cho thấy: Sự "ba phải" của AI như ChatGPT đang cuốn người dùng vào vòng xoáy hoang tưởng